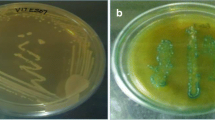

Abstract
The β-galactosidase is an industrially valuable enzyme and used to hydrolyze the lactose into glucose and galactose. Considering the broad utility profile in food industry, β-galactosidase from Aspergillus nidulans was purified and characterized in term of its catalytic properties and stability. It displayed highest catalytic efficiency at 60 °C after 10.0 min within acidic pH environment (pH 5). The β-galactosidase exhibited 100% and 60% catalytic activity at 40 °C and 50 °C, respectively even after 120.0 min. The β-galactosidase activity was remained stable in the presence of Zn2+, Ni2+, and Mg2+ ions. The activity was also retained in all investigated organic solvents except DMSO at various ionic concentrations. The surfactants Triton X-100 and SDS caused positive impact on the catalytic activity of enzyme at 1.0 mM concentration. However, the percent relative activity of β-galactosidase was significantly reduced when incubated with EDTA. The molecular mass of β-galactosidase estimated to be 95 kDa. The SEM micrographs of ONPG before and after β-galactosidase treatment indicated a remarkable difference in the morphology and proved the strong catalytic strength of enzyme. The β-galactosidase also demonstrated exceptional storage stability at − 80 °C, − 20 °C and 4 °C by retaining 86, 79 and 70% activity even after 100.0 days.
Similar content being viewed by others
Explore related subjects
Discover the latest articles, news and stories from top researchers in related subjects.Avoid common mistakes on your manuscript.
Introduction
β-Galactosidases (E.C.3.2.1.23, Lactase) regulate the hydrolytic process of lactose by cleaving the terminal non-reducing β-d-galactose components. Due to this catalytic property, β-galactosidase is widely employed in different biotechnological processes of food industry. It is involved to convert the lactose into β-glucose and β-galactose which are further used to synthesize sugar syrups (Pereira-Rodríguez et al. 2012). The technological and sensorial properties of food can be enhanced through biocatalysis of lactose. This process is also important to improve the creaminess of ice cream and texture of various baked products. Moreover, the monosaccharides released after the hydrolysis of lactose increase the sweetness of the product (Mlichová and Rosenberg 2006). β-Galactosidase is utilized in dairy industry to generate lactose-free milk products that is an efficient strategy in order to overcome the problem of lactose intolerant population worldwide (Harju et al. 2012; Alikkunju et al. 2016). The transglycosylation activity of β-galactosidase synthesizes water soluble galactooligosaccharides that are mostly incorporated in infant milk powders, yogurt and beverages to improve their flavor and multiplication of valuable bifidobacteria in the gastrointestinal tract (Karasová-Lipovová et al. 2003; Sako et al. 1999).
The efficient catalytic behavior and broad tolerance spectrum of enzyme against organic solvents, metal ions, high temperature and pH are responsible to broaden its utility profile at commercial level. The biochemical characterization of enzymes can boost up their catalytic efficiency over long period of time (Liu et al. 2015; Liao et al. 2016). Different microbial species are capable to release extracellular β-galactosidase but fungal strains are always preferred owing to the production of highly stable and catalytically efficient enzymes for industrial applications. The optimization of different chemical and physical parameters can further improve the catalytic performance of enzyme in order to attain the maximum product yield. Aspergillus species are mostly utilized to synthesize a large quantity of β-galactosidases that have different molecular masses and valuable catalytic properties (Sen et al. 2012; Wu et al. 2018; Raol et al. 2015). The new technologies such as protein engineering and computer based modeling are also very important to improve the major characteristics of enzymes with a remarkable catalytic efficiency and stability in order to fulfill their increasing demand for commercial use (Hecht 1996).
The current study was designed to examine the biochemical characteristics of β-galactosidase released from A. nidulans. Moreover, the impact of various metal ions, solvents and surfactants was analyzed on the catalytic efficiency of newly produced β-galactosidase. The molecular weight of enzyme was determined and storage stability was examined at different temperatures for prospective industrial use.
Materials and methods
β-Galactosidase synthesis from A. nidulans
The A. nidulans culture was previously isolated from the soil sample collected around the dairy farm for extracellular production of β-galactosidase (Kamran et al. 2017). The spores of 05 days old culture were used to prepare the seed culture. The seed culture (10.0 ml) was transferred into the optimized growth medium containing inoculum tube (90.0 ml) and kept for 03 days at 30 °C under anaerobic and static environment. In the next step, inoculum was shifted into the fermentation flask (900.0 ml) and incubated for 10.0 days at 30 °C. The fungal culture was harvested through centrifugation of fermented broth at 10,000 rpm for 15.0 min at 4 °C. Furthermore, the enzyme containing supernatant was passed through 0.45 µm filter paper (nitrocellulose, Millipore, Germany) under vacuum condition and stored at − 20 °C to execute the next partial purification step.
Partial purification and dialysis of β-galactosidase
The gradient precipitation technique was used for the partial purification of β-galactosidase from A. nidulans using 40.0–60.0% ammonium sulfate. The salt was added gradually in cell free filtrate (CFF) at 4 °C with constant mixing and kept for 18.0 h at the same temperature to equilibrate. The enzyme precipitates were obtained by centrifugation at 4 °C for 15.0 min at 1000 rpm and re-dissolved in 50.0 mM citrate buffer (pH 5.0). The catalytic activity and protein concentration of the enzyme were calculated after precipitation with each salt concentration (40.0–60.0%). Afterwards, the partially purified enzyme was dialyzed against the same buffer using dialysis tubing (Servapor®, Cut-off: 12,000 kDa) at 4 °C. The dialysis tube was initially kept in double deionized water for 1.0 h and was unfolded by gentle rubbing. After the addition of enzyme in the dialysis tube, both sides were tightly clipped to prevent any enzyme leakage and the tubes were placed in 50.0 mM citrate buffer (pH 5.0) containing beaker at 4 °C. The catalytic efficiency and protein concentration of dialyzed enzyme precipitates were estimated. The enzyme precipitates were stored at 4 °C for the next steps of biochemical characterization and molecular weight estimation.
β-galactosidase activity determination
The catalytic activity of β-galactosidase was analyzed by mixing the enzyme (200.0 µl) with 1.0 ml of O-nitrophenyl-β-d-galactopyrinoside (1.5 mg/ml) and the reaction mixture was incubated at 60 °C for 10.0 min. Afterwards, 1.0 ml of 10.0% Na2CO3 was added in the reaction tubes in order to cease the reaction. The amount of O-nitrophenol (ONP) synthesized after the biocatalytsis of O-nitrophenyl-β-d-galactopyrinoside (ONPG) was estimated at 420 nm (Onishi and Tanaka 1995). One unit of β-galactosidase represents the quantity of enzyme that releases 1.0 µmol ONP under standard reaction conditions.
Total protein concentration
The concentration of total protein was measured through Lowry’s method and bovine serum albumin was used as a reference protein (Lowry et al. 1951).
Effect of reaction time on the catalytic properties
The effect of reaction time was examined by incubating the enzyme (200.0 µl) with 1.0 ml of O-nitrophenyl-β-d-galactopyrinoside (ONPG) for different time period ranging from 5.0 to 60.0 min. The synthesized end product was analyzed by following the standard assay procedure as mentioned above.
Impact of temperature on the catalytic properties
The catalytic property of β-galactosidase was evaluated at different temperatures (40–80 °C) with constant reaction time (10.0 min) and substrate concentration (1.5 mg/ml) in order to attain the optimum reaction temperature for the maximum product synthesis. The shaking water baths (Thermo Fisher Scientific™) were used in this experiment for each temperature level. The catalytic activity of β-galactosidase was assessed by incubating it with substrate at 40–80 °C for 10.0 min. Afterwards, the same protocol as discussed earlier was used to complete the entire enzyme assay procedure.
Thermal stability
The thermal stability of β-galactosidase was analyzed by pre-incubating it at 40–70 °C for 120.0 min. After every 30.0 min, the enzyme was retrieved and assay was performed to examine its stability profile for potential industrial use.
Influence of pH and ionic capability of buffer on the catalytic properties
The impact of pH on the catalytic efficiency of β-galactosidase was examined by conducting the reaction within different pH environments (3.0–8.0) whereas, the temperature (60 °C) and substrate concentration (1.5 mg/ml) were kept constant. Different buffers (acetate buffer: pH 3.0–5.0; potassium phosphate buffer: pH 6.0–8.0) with 50.0 mM ionic strength were used in this experiment. The influence of the ionic strengths of the selected buffer was examined on β-galactosidase activity by performing the assay with different concentrations (10.0–100.0 mM) of selected sodium acetate buffer however, the pH was kept constant (pH 5.0).
Impact of solvents, surfactants, metal ions and metal ions chelator on the catalytic properties
The influence of different concentrations (1.0 mM, 5.0 mM and 10.0 mM) of various solvents, surfactants and metal ions (Cs+, Na+, K+, Mn2+, Cu2+, Co2+, Ca2+, Mg2+, Fe2+, Hg2+, Ni2+, Zn2+ and Ba2+) was analyzed on the β-galactosidase activity by incubating the equal quantity of both reactants (1:1) at 37 °C for 30.0 min and the enzyme assay was performed through standard test procedure as described earlier.
Storage stability
The stability profile of β-galactosidase was examined by storing the enzyme at 37 °C, 4 °C, − 20 °C, and − 80 °C for 100.0 days. The enzymatic activity was estimated on daily basis in terms of percent residual activity.
Molecular mass estimation and In-situ electrophoresis of β-galactosidase
Native-Polyacrylamide gel electrophoresis (Native-PAGE) was performed to estimate the molecular mass of β-galactosidase. The migration rate of the partially purified and dialyzed enzyme was compared with standard protein bovine serum albumin (BSA). Initially, the equal quantity (1:1) of enzyme and sample diluting buffer was mixed. This mixture was loaded onto a 12.0% polyacrylamide gel and electrophoresis was performed at 80.0 mV. The gel was stained using Coomassie brilliant blue R-250 and destained in order to attain the clear background around the protein bands. Slightly upgraded protocol of Pan et al. (1989) was used for In-situ electrophoresis of β-galactosidase. Initially, the gel was washed thrice with double deionized water and acetate buffer buffer (pH 5.0; 50.0 mM) after electrophoresis. After that, the gel was incubated with X-gal (dissolved in dimethylsulfoxide) at 37 °C overnight and the blue green band of β-galactosidase was observed. An approximate molecular weight of β-galactosidase was determined using gel documentation system with Quantity One Quantitative software (Bio-Rad Gel Doc™ 2000).
Scanning electron microscopy
The topographical analysis of substrate (O-nitrophenyl-β-d-galactopyrinoside) before and after the enzyme treatment was performed through scanning electron microscope (JSM 6380A Jeol, Japan). The samples were sputter coated with gold by placing them in the quick auto coater and the micrographs were taken at different magnification scales (2500×, 3000×, 5000×, 7000×).
Statistical analysis
All the experiments were conducted in triplicates and the data presented are a mean value of three observations. The data was analyzed through Bonferroni test for the calculation of significant difference and the significant level was adjusted at P < 0.05.
Results and discussion
Partial purification and dialysis of β-galactosidase
In the current study, β-galactosidase released from A. nidulans was partially purified using ammonium salt by following the gradient precipitation approach. The optimum salt saturation is capable to purify and concentrate the β-galactosidase by changing its solubility within the cell free filtrate mixture. Various concentrations of ammonium sulfate ranging from 40.0 to 60.0% were added gradually in the crude enzyme on ice bath and continuously mixed to reduce the effect of the heat generated during the entire process. It was found that 50.0% concentration of the ammonium sulfate was enough for the precipitation of β-galactosidase with the maximum specific activity (Table 1). However, it was reported earlier that the β-galactosidase from Bacillus safensis JUCHE 1 was purified on the same salting-out principle using 40.0% ammonium salt concentration (Nath et al. 2013). The concentration of the salt for enzyme precipitation may vary due to different molecular weights of enzymes. A purification approach can be made more efficient if different physical and chemical properties including optimal pH, molecular mass, isoelectric point of the enzyme are known (Dako et al. 2012). It was observed that the fold purification improved as the catalytic activity of β-galactosidase increased and enzyme precipitates showed 505.0 U mg−1 specific activity with 8.4 fold purification. Whereas, dialyzed precipitates showed 928.8 U mg−1 specific activity with 15.5 fold purification. The recovery of the enzyme precipitates was improved after dialysis from 40.7 to 50.6%. The β-galactosidase from different sources was purified to different extent. The β-galactosidase from Anoxybacillus sp. KP1 was purified to 14.4 fold with 11.8% yield and 1632.1 U mg−1 specific activity (Bekler et al. 2017). Whereas β-galactosidase from Pediococcus acidilactici was purified to 3.06 fold with the yield of 28.26% and 0.883 U mg−1 specific activity (Chanalia et al. 2018). In the current study, the complete purification process of β-galactosidase from A. nidulans generated 15.5 fold purified enzyme with 50.6% recovery rate (Table 2).
Impact of reaction time on the catalytic properties
The catalytic efficiency of enzyme was examined by incubating it with substrate from 5.0 to 25.0 min at 50 °C. It was noticed that the percent relative activity of β-galactosidase increased as the reaction time increased and the highest activity achieved after 10.0 min of reaction period (Fig. 1a). A gradual decrease in the percent relative activity was observed as the reaction time increased after optimal level (10.0 min). The β-galactosidase indicated 98% and 92% activity after 15.0 and 25.0 min of reaction periods, respectively. The minimum reaction time is preferred to be used in different bioprocesses of food industry in order to attain the maximum product yield within a short time. A survey of the literature showed that the reaction time of the enzymes varies due to their specific structural conformation. It was found that the pectinase from Bacillus licheniformis KIBGE-IB21 showed the maximum hydrolysis of pectin after 5.0 min whereas dextranase from Leuconostoc mesenteroides indicated its highest catalytic activity toward its substrate after 15.0 min (Rehman et al. 2013; Qader et al. 2007).
Impact of temperature on the catalytic properties
Temperature is the key factor that can alter the catalytic efficiency of any enzyme at industrial level. The heat tolerating capability of β-galactosidase was assessed by incubating the enzyme at different temperatures (40–80 °C). It was noticed that the β-galactosidase activity accelerated as the temperature increased and reached to its optimal level at 60 °C. However, further increment in the temperature reduced the catalytic activity of enzyme (Fig. 1b). The reactants interact well with each other at high temperature due to the high kinetic energy but the extreme increase in the kinetic behavior may cause enzyme denaturation by cleaving the peptide bonds present to maintain the three dimensional structure of the protein (Rehman et al. 2015). The temperature optima of the β-galactosidase varies among different microbial species. The β-galactosidase from psychrotolerant yeast Guehomyces pullulans 17-1 and H. lacusprofundi displayed the temperature optima at 50 °C whereas, β-galactosidase synthesized from Thermomyces lanuginosus was completely stable at 47 °C (Song et al. 2010; Karan et al. 2013; Fischer et al. 1995).
Thermal stability
The stability profile of the β-galactosidase against different temperatures and incubation times was investigated that indicated the ability of enzyme to resist the thermal degradation in the absence of substrate. This capability is a prerequisite to be used in different industrial bioprocess where harsh conditions mostly exist (Bhatti et al. 2006). It was noticed that β-galactosidase from A. nidulans was stable at 40 °C with retention of 100% activity after 120.0 min (Fig. 1c). The stability of β-galactosidase was gradually decreased as the temperature increased and a decline of 40% and 95% in initial activity was noticed at 50 °C and 60 °C, respectively after 120.0 min. The percent residual activity of enzyme further reduced at 70 °C and enzyme retained only 16% activity after 60.0 min however, no activity was observed after 90.0 min. The high heat tolerating enzymes are mostly preferred in different industries because they can survive in the reaction mixture for long time and release the maximum product within short time due to the high kinetic energy. Thermal stability is also one of the important factors that is always considered for the commercialization of any enzyme (Rehman et al. 2015). The addition of thermostable enzymes during the extraction process of fruits and vegetables juices at 50 °C improves the release of colored compounds from the fruits and vegetables mesh networks (Lozano and Jorge 2006). The thermostable β-galactosidase can be employed for the processing of different milk products at high temperature levels. It was found in the current study that β-galactosidase from A. nidulans is more excellent candidate for food and other industrial processes due to the broad thermal stability profile as compared to previous reports where the same enzyme from Pseudoalteromonas sp. 22b lost its all catalytic activity within 10.0 min at 50 °C (Cieśliński et al. 2005). In the same way, β-galactosidase from Penicillium chrysogenum NCAIM 00237 showed its optimum activity at 30 °C and further increment in temperature declined the activity (Nagy et al. 2001).
Influence of pH and ionic capability of buffer on the catalytic properties
The pH of the reaction mixture is a crucial factor to maintain the stability of the enzyme in any industrial bioprocess. It was observed that A. nidulans β-galactosidase was active over a wide range of pH levels. However, it exhibited more stability towards acidic environment and retained about 80% relative activity between pH 4.0–6.0 with the highest activity at pH 5.0 (Fig. 1d). The acidic nature of the enzyme indicated its excellent behavior to be used in food industry because pH values of fruit juices are lower than 5.0. The acidic β-galactosidase can be used to improve the texture and flavor of the fruit juices, ice cream, butter, cheese and yogurt due to lower pH of these products (Lozano and Jorge 2006; Chanalia et al. 2018). Further increase in pH to alkaline condition drastically decreased the catalytic behavior of β-galactosidase and it almost reduced 80% activity at pH 8.0. It was reported that β-galactosidase from B. licheniformis DSM 13 displayed its maximum catalytic activity when the reaction pH reached up to 6.5 however, β-galactosidase from B. megaterium indicated its high activity at pH 7.5–8.0 (Juajun et al. 2011; Li et al. 2009). The same pH optima (7.5) of β-galactosidase from Bifidobacterium infantis HL96 was achieved for O-nitrophenyl-β-d-galactopyrinoside (ONPG) and lactose hydrolysis (Hung and Lee 2002). The effect of various ionic strengths of the selected acetate buffer having pH 5.0 was also investigated on the catalytic activity of β-galactosidase. It was observed that the percent relative activity of enzyme improved as the ionic strength of the buffer increased from 0.01 to 0.05 M and the highest activity was attained when ionic concentration reached up to 0.06 M (Fig. 1e). Further increment in the ionic strength of the buffer caused a gradual decline with 98% and 70% relative activity at 0.07 M and 1.0 M concentrations, respectively. The enzyme and substrate based reactions depend on the ionic strength of the buffer and the availability of the charged molecules. The buffer ions paly pivotal role during the binding of charged groups of substrate to the catalytic sites of the enzyme. Consequently, the acetate buffer with 0.06 M ionic strength was observed as a suitable choice for the movement and binding of O-nitrophenyl-β-d-galactopyrinoside to the active sites of β-galactosidase.
Impact of solvents, surfactants, metal ions and metal ions chelator on the catalytic properties
The enzymes mostly face unfavorable reaction conditions when used in different industrial bioprocesses. They must have ability to tolerate extreme reaction conditions. Therefore, the stability profile of β-galactosidase was investigated in the presence of different solvents, surfactants, metal ions and ions chelator having different ionic concentrations. It was found that all organic solvents except DMSO caused positive impact on the β-galactosidase by maintaining its catalytic activity at 1.0 mM and 5.0 mM concentrations. However, the activity was reduced when the concentration exceeded up to 10.0 mM (Table 3). It has been documented that the β-galactosidase from Halorubrum lacusprofundi was stable in alcoholic solution containing 10-20% methanol, ethanol, butanol or isoamyl alcohol (Karan et al. 2013). Various concentrations (1.0 mM, 5.0 mM and 10.0 mM) of different surfactants were also examined in order to find out their stimulatory or inhibitory impact on the catalytic efficiency of β-galactosidase. It was observed that Tween 80 maintained the percent relative activity of β-galactosidase at all concentrations however, Triton X-100 and SDS declined the percent relative activity of enzyme when 5.0 mM and 10.0 mM concentrations were used. It was noticed that all metal ions with different concentrations (1.0 mM, 5.0 mM and 10.0 mM) generated inhibitory effect on β-galactosidase activity except Zn2+, Ni2+ and Mg2+ ions. In another finding, the divalent cations Mg2+, Mn2+ and Ca2+ were found as activators that enhanced the catalytic property of β-galactosidase from B. licheniformis DSM 13 at 1.0 mM concentration (Juajun et al. 2011). The Hg2+ ions showed highest inhibition and declined the activity of β-galactosidase up to 72% when 10.0 mM concentration was tested. It has been mentioned in an earlier report that the catalytic property of β-galactosidase from Prunus persica inhibited with Hg2+ ions (Lee et al. 2003). The percent relative activity of β-galactosidase was decreased in EDTA containing reaction mixture. It was evident from the current result that the β-galactosidase from A. nidulans belongs to a metallo-enzymes family that requires specific metal ions in order to accelerate the catalytic reaction. In the previous study, the EDTA and urea were also found as an inhibitors when incubated with β-galactosidase from Bifidobacterium infantis HL96 (Hung and Lee 2002).
Storage stability
The shelf life of any enzyme indicates that how long it maintains its initial activity at various storage temperatures. It was noticed that the β-galactosidase from A. nidulans showed high storage stability at − 80 °C by retaining 86% activity after 100.0 days. The storage stability slightly reduced when the enzyme was kept at − 20 °C and 4 °C where it displayed 79% and 70% of its initial activity respectively, even after 100.0 days (Fig. 1f). The reduction in the catalytic activity of β-galactosidase at different storage temperatures could be due to the autolysis or unfolding of its three dimensional structure. It was observed earlier that the polygalacturonase from Bacillus licheniformis retained 100% catalytic activity when stored at − 20 °C for 30 days whereas, 95% activity was attained at 4 °C (Rehman et al. 2015). It was found that a drastic change in the catalytic activity of maltase appeared when kept at 30 °C for 60 days which lost 63% of its initial activity (Nawaz et al. 2015).
Molecular mass estimation and In-situ electrophoresis
The molecular mass and hydrolytic activity pattern of the enzyme were analyzed through Native-Polyacrylamide gel electrophoresis and in-situ electrophoresis, respectively. A clear hydrolytic band of the partially purified β-galactosidase was observed against a substrate X-gal with 95 kDa molecular mass (Fig. 2). Various microbial and plants species produce a variety of enzymes with different molecular weights. The purified β-galactosidase isolated from peach was 42 kDa in molecular mass whereas, the xylanase from Chaetomium sp. CQ31 showed 25.1 kDa molecular mass (Lee et al. 2003; Jiang et al. 2010). The molecular mass of the recombinant β-galactosidase from Thermotoga naphthophila was estimated to be 79.0 kDa (Yang et al. 2015) however, the molecular mass of the β-galactosidase from Pediococcus acidilactici as measured by the SDS-PAGE and MALDI-TOF was 39.07 kDa (Chanalia et al. 2018).
Scanning electron microscopy
The topographical analysis of O-nitrophenyl-β-d-galactopyrinoside before and after β-galactosidase treatment was carried out through scanning electron microscopy at different magnification scales (2500×, 3000×, 5000×, 7000×). The micrograph results displayed the difference in the morphology of O-nitrophenyl-β-d-galactopyrinoside before and after the enzymatic treatment. The smooth and porous external surface of the untreated substrate was observed at 2500×, 3000×, 5000×and 7000× (Fig. 3a, c, e, g). However, after β-galactosidase treatment the pores and the outer entire surface of substrate were seemed to be occupied by the irregular particles at various magnification scales (Fig. 3b, d, f, h). Such particles might be enzyme aggregates and end product released during the enzyme–substrate reaction. The most significant change on the surface morphology of the rice straw was also observed through scanning electron microscope after α-L-arabinofuranosidase treatment. The outer structure of the rice straw was regular and compact prior to the enzymatic treatment however, it became hollower, chapped and cracked after enzymatic action (Kurniati et al. 2016).
Conclusion
The present study is an effort made to purify and characterize the commercially employed β-galactosidase from A. nidulans. The results displayed some interesting properties of β-galactosidase with broad thermal and pH stability profile. The enzyme was more active at high temperature and acidic pH environment that indicated its broad efficacy to be used in processing of milk, fruit juices and bakery products. This enzyme can work with various organic solvents, surfactants and metal ions which improve its applications in different industrial bioprocesses. An efficient catalytic behavior of the β-galactosidase at different storage temperatures boosts up its utility profile for the routine laboratory use as well.
References
Alikkunju AP, Sainjan N, Silvester R, Joseph A, Rahiman M, Antony AC, Kumaran RC, Hatha M (2016) Screening and characterization of cold-active β-galactosidase producing psychrotrophic Enterobacter ludwigii from the sediments of Arctic Fjord. Appl Biochem Biotechnol 180:477–490. https://doi.org/10.1007/s12010-016-2111-y
Bekler FM, Yalaz S, Acer O, Guven K (2017) Purification of thermostable β-galactosidase from Anoxybacillus sp. KP1 and estimation of combined effect of some chemicals on enzyme activity using semiparametric errors in variables model. Fresenius Environ Bull 26:2251–2259
Bhatti HN, Asgher M, Abbas A, Nawaz R, Sheikh MA (2006) Studies on kinetics and thermostability of a novel acid invertase from Fusarium solani. J Agric Food Chem 54:4617–4623
Chanalia P, Gandhi D, Attri P, Dhanda S (2018) Purification and characterization of β-galactosidase from probiotic Pediococcus acidilactici and its use in milk lactose hydrolysis and galactooligosaccharide synthesis. Bioorg Chem 77:176–189
Cieśliński H, Kur J, Białkowska A, Baran I, Makowski K, Turkiewicz M (2005) Cloning, expression, and purification of a recombinant cold-adapted β-galactosidase from Antarctic bacterium Pseudoalteromonas sp. 22b. Protein Expr Purif 39:27–34
Dako E, Dadie AT, Bernier A-M, Jankowski CK (2012) The problems associated with enzyme purification. In: Ekinci D (ed) Chemical biology. INTECH Open Access Publisher, London, pp 19–40
Fischer L, Scheckermann C, Wagner F (1995) Purification and characterization of a thermotolerant beta-galactosidase from Thermomyces lanuginosus. Appl Environ Microbiol 61:1497–1501
Harju M, Kallioinen H, Tossavainen O (2012) Lactose hydrolysis and other conversions in dairy products: technological aspects. Int Dairy J 22:104–109
Hecht MH (1996) Strategies for the design of novel proteins. In: Carey P (ed) Protein engineering and design. Academic Press, New York, pp 1–50
Hung MN, Lee B (2002) Purification and characterization of a recombinant β-galactosidase with transgalactosylation activity from Bifidobacterium infantis HL96. Appl Microbiol Biotechnol 58:439–445
Jiang Z, Cong Q, Yan Q, Kumar N, Du X (2010) Characterization of a thermostable xylanase from Chaetomium sp. and its application in Chinese steamed bread. Food Chem 120:457–462
Juajun O, Nguyen T, Maischberger T, Iqbal S, Haltrich D, Yamabhai M (2011) Cloning, purification, and characterization of β-galactosidase from Bacillus licheniformis DSM 13. Appl Microbiol Biotechnol 89:645–654
Kamran A, Bibi Z, Aman A, Qader SAU (2017) Hyper production of β-galactosidase from newly isolated strain of Aspergillus nidulans. J Food Proc Eng 40:12452. https://doi.org/10.1111/jfpe.12452
Karan R, Capes MD, DasSarma P, DasSarma S (2013) Cloning, overexpression, purification, and characterization of a polyextremophilic β-galactosidase from the Antarctic haloarchaeon Halorubrum lacusprofundi. BMC Biotechnol 13:3. https://doi.org/10.1186/1472-6750-13-3
Karasová-Lipovová P, Strnad H, Spiwok V, Malá Š, Králová B, Russell NJ (2003) The cloning, purification and characterisation of a cold-active β-galactosidase from the psychrotolerant Antarctic bacterium Arthrobacter sp. C2-2. Enzyme Microb Technol 33:836–844
Kurniati A, Darmokoesoemo H, Puspaningsih NNT (2016) Scanning electron microscope analysis of rice straw degradation by a treatment with α-L-arabinofuranosidase. Proc Chem 18:63–68
Lee DH, Kang SG, Suh SG, Byun JK (2003) Purification and characterization of a beta-galactosidase from peach (Prunus persica). Mol Cells 15:68–74
Li Y, Wang H, Lu L, Li Z, Xu X, Xiao M (2009) Purification and characterization of a novel β-galactosidase with transglycosylation activity from Bacillus megaterium 2-37-4-1. Appl Biochem Biotechnol 158:192–199
Liao X, Zheng Q, Zhou Q, Lin J, Guo L, Yun F (2016) Characterization of recombinant β-galactosidase and its use in enzymatic synthesis of lactulose from lactose and fructose. J Mol Catal B Enzym 134:253–260
Liu Z, Zhao C, Deng Y, Huang Y, Liu B (2015) Characterization of a thermostable recombinant β-galactosidase from a thermophilic anaerobic bacterial consortium YTY-70. Biotechnol Biotechnol Equip 29:547–554. https://doi.org/10.1080/13102818.2015.1015244
Lowry OH, Rosebrough NJ, Farr AL, Randall RJ (1951) Protein measurement with the folin phenol reagent. J Biol Chem 193:265–375
Lozano JE (2006) Processing of fruits: ambient and low temperature processing. In: Fruit manufacturing. Springer, Boston, MA, pp. 21–54. https://doi.org/10.1007/978-0-387-30616-2_2
Mlichová Z, Rosenberg M (2006) Current trends of β-galactosidase application in food technology. J Food Nutr Res 45:47–54
Nagy Z, Kiss T, Szentirmai A, Biró S (2001) β-Galactosidase of Penicillium chrysogenum: production, purification, and characterization of the enzyme. Protein Expr Purif 21:24–29
Nath A, Chakrabarty S, Sarkar S, Bhattacharjee C, Drioli E, Chowdhury R (2013) Purification and characterization of β-galactosidase synthesized from Bacillus safensis (JUCHE 1). Ind Eng Chem Res 52:11663–11672
Nawaz MA, Karim A, Aman A, Marchetti R, Qader SA, Molinaro A (2015) Continuous degradation of maltose: improvement in stability and catalytic properties of maltase (α-glucosidase) through immobilization using agar-agar gel as a support. Bioprocess Biosyst Eng 38:631–638
Onishi N, Tanaka T (1995) Purification and properties of a novel thermostable galactooligosaccharide-producing betagalactosidase from Sterigmatomyces elviae (CBS8119). Appl Environ Microbiol 61:4026–4030
Pan SQ, Ye XS, Kue J (1989) Direct detection of β-1,3-glucanase isozymes on polyacrylamide electrophoresis and isoelectrofocusing gels. Anal Biochem 182:136–140
Pereira-Rodríguez Á, Fernández-Leiro R, González-Siso MI, Cerdán ME, Becerra M, Sanz-Aparicio J (2012) Structural basis of specificity in tetrameric Kluyveromyces lactis β-galactosidase. J Struct Biol 177:392–401
Qader SAU, Aman A, Syed N, Bano S, Azhar A (2007) Characterization of dextrasucrase immobilized on calcium alginate beads from Leuconostoc mesenteroides PCSIR-4. Ital J Biochem 56:158–162
Raol GG, Raol BV, Prajapati VS, Patel KC (2015) Kinetic and thermodynamic characterization of a halotolerant β-galactosidase produced by halotolerant Aspergillus tubingensis GR1. J Basic Microbiol 54:1–11
Rehman HU, Aman A, Silipo A, Qadar SAU, Molinaro A, Ansari A (2013) Degradation of complex carbohydrate: immobilization of pectinase from Bacillus licheniformis KIBGE-IB21 using calcium alginate as a support. Food Chem 139:1081–1086
Rehman HU, Aman A, Nawaz MA, Qader SAU (2015) Characterization of pectin degrading polygalacturonase produced by Bacillus licheniformis KIBGE-IB21. Food Hydrocoll 43:819–824
Sako T, Matsumoto K, Tanaka R (1999) Recent progress on research and applications of nondigestible galactooligosaccharides. Int Diary J 9:69–80
Sen S, Ray L, Chattopadhyay P (2012) Production, purification, immobilization, and characterization of a thermostable β-galactosidase from Aspergillus alliaceus. Appl Biochem Biotechnol 167:1938–1953. https://doi.org/10.1007/s12010-012-9732-6
Song C, Liu G, Xu J, Chi Z (2010) Purification and characterization of extracellular β-galactosidase from the psychrotolerant yeast Guehomyces pullulans 17-1 isolated from sea sediment in Antarctica. Process Biochem 45:954–960
Wu H, Cheng X, Zhu Y, Zeng W, Chen G, Liang Z (2018) Purification and characterization of a cellulase-free, thermostable endo-xylanase from Streptomyces griseorubens LH-3 and its use in biobleaching on eucalyptus kraft pulp. J Biosci Bioeng 125:46–51. https://doi.org/10.1016/j.jbiosc.2017.08.006
Yang J, Di X, Wang M, Gao R (2015) Gene clone and characterization of a novel thermostable β-galactosidase with transglycosylation activity from Thermotoga naphthophila RUK-10. Chem Res Chin Univ 31:564–568
Acknowledgements
This research work was financially supported by the Karachi Institute of Biotechnology and Genetic Engineering (KIBGE), University of Karachi, Karachi-75270, Pakistan.
Author information
Authors and Affiliations
Corresponding author
Rights and permissions
About this article
Cite this article
Kamran, A., Bibi, Z., Aman, A. et al. Purification and catalytic behavior optimization of lactose degrading β-galactosidase from Aspergillus nidulans. J Food Sci Technol 56, 167–176 (2019). https://doi.org/10.1007/s13197-018-3470-x
Revised:
Accepted:
Published:
Issue Date:
DOI: https://doi.org/10.1007/s13197-018-3470-x